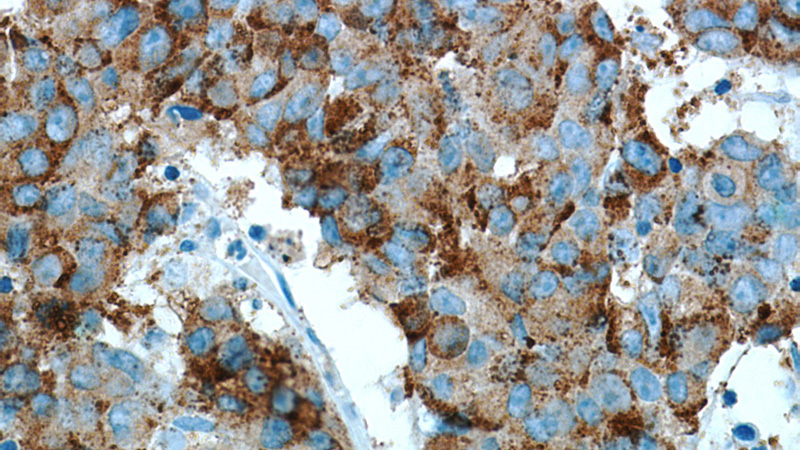
Immunohistochemical of paraffin-embedded human prostate cancer using Catalog No:107987(p504S,AMACR antibody) at dilution of 1:50 (under 40x lens). Heat mediated antigen retrieved with Citric acid buffer, pH6.0

-
Product Name
AMACR/p504S antibody
- Documents
-
Description
AMACR/p504S Rabbit Polyclonal antibody. Positive WB detected in multi-cells. Positive IHC detected in human prostate cancer tissue, human renal cell carcinoma tissue. Observed molecular weight by Western-blot: 42 kDa
-
Tested applications
ELISA, IHC, WB
-
Species reactivity
Human; other species not tested.
-
Alternative names
2 methylacyl CoA racemase antibody; alpha methylacyl CoA racemase antibody; AMACR antibody; CBAS4 antibody; p504S antibody; RACE antibody
-
Isotype
Rabbit IgG
-
Preparation
This antibody was obtained by immunization of AMACR/p504S recombinant protein (Accession Number: NM_203382). Purification method: Antigen affinity purified.
-
Clonality
Polyclonal
-
Formulation
PBS with 0.1% sodium azide and 50% glycerol pH 7.3.
-
Storage instructions
Store at -20℃. DO NOT ALIQUOT
-
Applications
Recommended Dilution:
WB: 1:500-1:5000
IHC: 1:20-1:200
-
Validations

WB result of Catalog No:107987(anti-P504S,AMACR) from Dr. Soory.

Immunohistochemical of paraffin-embedded human prostate cancer using Catalog No:107987(p504S,AMACR antibody) at dilution of 1:50 (under 10x lens). Heat mediated antigen retrieved with Citric acid buffer, pH6.0
Immunohistochemical of paraffin-embedded human prostate cancer using Catalog No:107987(p504S,AMACR antibody) at dilution of 1:50 (under 40x lens). Heat mediated antigen retrieved with Citric acid buffer, pH6.0
-
Background
AMACR(Alpha-methylacyl-CoA racemase) belongs to the CaiB/BaiF CoA-transferase family. It is a mitochondrial and peroxisomal enzyme that catalyzes the conversion of 2R stereoisomers of phytanic and pristanic acid to their S counterparts. AMACR has previously been shown to be a highly sensitive marker for colorectal and clinically localized prostate cancer (PCa). However, AMACR expression is down-regulated at the transcript and protein level in hormone-refractory metastatic PCa, suggesting a hormone-dependent expression of AMACR(PMID:12213712). It has 3 isoforms produced by alternative splicing ang it can form a a dimer of 70-75 kDa(PMID:21812041). Defects in AMACR are the cause of alpha-methylacyl-CoA racemase deficiency (AMACRD) and congenital bile acid synthesis defect type 4 (CBAS4).
Related Products / Services
Please note: All products are "FOR RESEARCH USE ONLY AND ARE NOT INTENDED FOR DIAGNOSTIC OR THERAPEUTIC USE"
